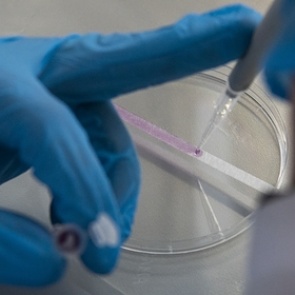
Российские ученые разработали тест для диагностики рака по выдыхаемому воздуху

Вы неправильно спите: для чего нам нужен сон, полезно ли спать днем и как понять, что не дышишь во сне 0
6 мая 2020 - Melissa
| 1093 просмотра
Теги: сегодня, новости, новости, красноярский край, коронавирус, карантин, город, ачинск
Читать далее...
Теги: сегодня, новости, новости, красноярский край, коронавирус, карантин, город, ачинск
5 привычек, которые вредят красоте 0
6 мая 2020 - Melissa
| 1085 просмотров
Теги: сегодня, новости, новости, красноярский край, коронавирус, карантин, город, ачинск
Читать далее...
Теги: сегодня, новости, новости, красноярский край, коронавирус, карантин, город, ачинск
Российские ученые разработали тест для диагностики рака по выдыхаемому воздуху 0
6 мая 2020 - Melissa
| 1045 просмотров
Теги: сегодня, новости, новости, красноярский край, коронавирус, карантин, город, ачинск
Читать далее...
Теги: сегодня, новости, новости, красноярский край, коронавирус, карантин, город, ачинск
Объяснена причина слабого иммунитета у современных людей 0
4 мая 2020 - Melissa
| 1267 просмотров
Теги: сегодня, самоизоляция, новости, новости, красноярский край, коронавирус, карантин, город, ачинск
Читать далее...
Теги: сегодня, самоизоляция, новости, новости, красноярский край, коронавирус, карантин, город, ачинск
Ученый назвал условие появления иммунитета к коронавирусу 0
4 мая 2020 - Melissa
| 1288 просмотров
Теги: сегодня, самоизоляция, новости, новости, красноярский край, коронавирус, карантин, город, ачинск
Читать далее...
Теги: сегодня, самоизоляция, новости, новости, красноярский край, коронавирус, карантин, город, ачинск
Забудьте о мясе и шоколаде: 8 продуктов, которые убивают иммунитет 0
4 мая 2020 - Melissa
| 1400 просмотров
Теги: сегодня, новости, новости, красноярский край, короновирус, город, ачинск
Читать далее...
Теги: сегодня, новости, новости, красноярский край, короновирус, город, ачинск
7 микроэлементов, без которых волосы не будут сильными, а кожа – сияющей 0
3 мая 2020 - Marishka
| 1026 просмотров
Читать далее...
Роспотребнадзор назвал отличие симптомов сезонной аллергии от коронавируса 0
2 мая 2020 - Marishka
| 1202 просмотра
Теги: сегодня, самоизоляция, новости, новости, красноярский край, коронавирус, карантин, город, ачинск
Читать далее...
Теги: сегодня, самоизоляция, новости, новости, красноярский край, коронавирус, карантин, город, ачинск
Названы возможные плюсы коронавируса 0
30 апреля 2020 - Melissa
| 1067 просмотров
Теги: сегодня, новости, новости, красноярский край, коронавирус, карантин, город, ачинск
Читать далее...
Теги: сегодня, новости, новости, красноярский край, коронавирус, карантин, город, ачинск
В Кремле оценили российские тесты на коронавирус 0
30 апреля 2020 - Melissa
| 1109 просмотров
Теги: сегодня, новости, новости, красноярский край, коронавирус, карантин, город, ачинск
Читать далее...
Теги: сегодня, новости, новости, красноярский край, коронавирус, карантин, город, ачинск